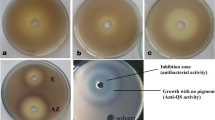

Abstract
Antibiotics are usually used for the treatment of bacterial infections, but multidrug-resistant strains are a phenomenon that has been growing at an increasing rate worldwide. Thus, there is an increasing need for novel strategies for combatting infectious diseases. Many pathogenic bacteria apply quorum sensing (QS) to regulate their pathogenicity and virulence factors production. This circuit makes the QS system an attractive target for antibacterial therapy. In the present study, an important member of non-steroidal anti-inflammatory drugs (NSAIDs), by reducing the biofilm and producing QS-regulated virulence factors, ketoprofen and its synthetic derivatives were screened against the Pseudomonas aeruginosa PAO1. All compounds showed anti-biofilm activity (16–79%) and most of them presented anti-virulence activity. In the co-treatment of ketoprofen, G20, G21, or G77 with tobramycin, biofilm is significantly reduced (potentiated to > 50%) in the number of cells protected inside the impermeable matrix. The in silico studies in addition to the similarities between the chemical structures of PqsR natural ligands and ketoprofen derivatives reinforce the possibility that the mechanism of action is through PqsR inhibition. Based on the results, the anti-pathogenic effect was more appreciable in ketoprofen, G77, and G20.
Similar content being viewed by others
Avoid common mistakes on your manuscript.
Introduction
As the global emergence of multidrug-resistant (MDR) Pseudomonas aeruginosa has created a universal health problem, it is necessary to develop novel alternative approaches to overcome microbial infections (Qais et al. 2019). The antibiotics cannot be used for long-term therapies, either due to the growth of resistance against them or unfavorable effects on the host’s microbiome or both (Maisuria et al. 2016; Qais et al. 2019).
In the last decade, researchers have focused on selective interventions in bacterial virulence pathways to confront pathogenicity and infections of bacteria such as P. aeruginosa (Qais et al. 2019) through compounds that do not interfere with survival or growth; and thus, possibly result in less resistance than conventional antibiotics (Soheili et al. 2019).
P. aeruginosa is a laboratory model strain for studying biofilms as well as the main pathogen that participates in many chronic and commonly fatal infections, for instance, respirator-associated pneumonia, burn infections, and lung complications in patients with cystic fibrosis (CF) (Reichhardt and Parsek 2019). This pathogen produces a series of virulence factors, including extracellular proteases and toxins such as elastase, pyocyanin, alkaline protease, lectins, superoxide dismutase, exotoxin A, rhamnolipids and HCN, to overcome the defense of host cells (Soheili et al. 2015).
These virulence factors secreted by P. aeruginosa are controlled by a complex regulatory circuit including a cell-to-cell signaling system named quorum sensing (QS), which allows the bacteria to activate in a synchronized manner (Van Delden and Iglewski 1998). In fact, QS is a microorganism communication system inducing density-dependent responses. Through chemical signaling, it can manage gene expression (Rutherford and Bassler 2012). Such signaling mechanisms found in several species of microorganisms are responsible for different bacterial behaviors including conjugation, virulence, biofilm formation, bioluminescence, and cell differentiation that promote resistance (Bottomley et al. 2007; Dekimpe and Deziel 2009; Soheili et al. 2015). P. aeruginosa has three different QS systems, including LasI-LasR, RhlI-RhlR, and PQS-MvfR (PqsR), that rely on small signaling molecules called auto-inducers: N-acyl homoserine lactones N-(3-oxododecanoyl)-l-homoserine lactone (C12-HSL), N-butanoyl-l-homoserine lactone (C4-HSL) and 4-hydroxy-2-alkylquinolines, respectively (El-Mowafy et al. 2014; Bahari et al. 2017).
A microbial biofilm, consisting of exopolysaccharides, is a bacterial community that adheres to and grows on surfaces inside a polymeric matrix (Soheili et al. 2015). Biofilm formation supports microbes against unfavorable environments (Reichhardt and Parsek 2019). Naturally, biofilm microbes display reduced susceptibility to antimicrobial treatments compared to their planktonic counterparts (Reichhardt and Parsek 2019). Biofilm matrix arrangement varies based on the microbial species and also growth conditions. Generally, the biofilm matrix contains exopolysaccharides (EPS), extracellular DNA (eDNA), and proteins. These matrix elements are assembled into supramolecular structures that protect microbes against external stresses (Reichhardt and Parsek 2019).
QS inhibitors (QSIs) have a significant impact on acute or chronic infection treatment, reducing both P. aeruginosa pathogenesis and bacterial virulence. To date, some natural and synthetic compounds have been described as QSIs including halogenated furanone compounds from marine algae Delisea pulchra (Givskov et al. 1996) and penicillic acid and patulin from Penicillium species (Rasmussen et al. 2005). Ajoene, and sulfur-rich molecule from garlic (Jakobsen et al. 2012) in addition to ellagic acid from Terminalia chebula Retz. has also shown QSI effects (Sarabhai et al. 2013). Novel synthetic QSIs like N-acyl-homoserine lactones (AHLs) analogs including phenyloxyacetyl homoserine lactones and phenylpropionyl homoserine lactones were introduced (Geske et al. 2008), and also halogenated furanones and other furanone derivatives from cyclopentanols series are mentioned for their QS inhibitory effects (Hentzer et al. 2002; Kim et al. 2008; Bahari et al. 2017).
In the present study, we selected PqsR as a suitable target protein, since PqsR plays an important role in the P. aeruginosa QS cascade system. In several studies Non-Steroidal Anti-inflammatory drugs (NSAIDs) have been regarded as anti-pseudomonal compounds. Consequently, ketoprofen and its derivatives synthesized through another study were selected and investigated against PqsR (Kim et al. 2008; Zarghi and Ghodsi 2010). Moreover, the chemical structure similarity of ketoprofen derivatives and the natural PqsR ligands [Pseudomonas quinolone signal (PQS) and its chemical precursor, 4-Hydroxy-2-heptyl quinoline (HHQ)] motivated us to investigate their effects against both biofilm formation and virulence factors production. As shown in Fig. 1, these compounds are quinoline analogs of ketoprofen and they have been reported as potent and selective COX-2 inhibitors.
Materials and methods
Chemicals and materials
P. aeruginosa PAO1 (Nottingham wild type) was used in all tests. All experiments were conducted in Mueller–Hinton agar (MHA) and Mueller–Hinton broth (MHB) from HiMedia (India). Tobramycin was obtained from Sigma-Aldrich (USA). Ketoprofen was obtained from Temad Pharmaceutical Company (Iran). All ketoprofen derivatives were synthesized according to the previous study (Zarghi and Ghodsi 2010). Other chemicals including 2,3,5-Triphenyl tetrazolium chloride (TTC), chloroform, HCl, and skimmed milk were purchased from Merck (Germany).
Determination of the minimum inhibitory concentration (MIC)
Minimum inhibitory concentration (MIC) of ketoprofen and the related derivatives against P. aeruginosa was evaluated using TTC as reported earlier (Qais et al. 2019). Briefly, P. aeruginosa PAO1 was cultured in the presence of serial (twofold) dilutions of different compounds, from 1 mg/mL of each in Mueller–Hinton broth (MHB) supplemented with glucose as well as 7% DMSO as a co-solvent, in a 96-well microplate. Each well was inoculated with 20 µL of bacterial suspension (106 CFU/mL) and was incubated at 37 °C for 16 h. Then, 20 µl TTC (5 mg/mL) per well was added as an indicator to determine MIC. After incubation for 3 h at 37 °C, the wells which had turned to a red color indicated the presence of metabolically active cells, and the minimum concentration which had no change in color to red was taken as the MIC for each compound.
Biofilm formation
Inhibition of biofilm development was performed on a bottom flat 96-well microtiter plate as aforementioned (Husain et al. 2017; Qais et al. 2019). Briefly, 1 mg of each compound (0.5 mg for G69) was dissolved in 1860 µL glucose-enriched MHB medium supplemented with 140 µL DMSO. Moreover, 2 µg tobramycin was dissolved in glucose-enriched MHB medium in the same way. Then, 180 μL of each solution was inoculated to each well, separately. Subsequently, a 20 µL overnight culture of P. aeruginosa, adjusted to 106 CFU/mL was seeded into the wells. Wells inoculated by P. aeruginosa, without any treatment, were taken as the positive control group and the plate was incubated at 37 °C for 24 h under static conditions. Then, the culture medium of the wells was refreshed and incubated again. After 12 h, a fresh medium was again provided for the cells and incubated for another 12 h.
Subsequently, wells were drained and washed twice with normal saline. The formed biofilms were stained with 50 μL crystal violet (0.03% w/v) for 10 min and washed gently with normal saline to remove unbound dye. The bound crystal violet was solubilized in absolute ethanol. The absorbance of dye was recorded at 590 nm using a microplate reader (Synergy H4, USA). The % inhibition was calculated by the following equation:
Virulence factors assay
Pyocyanin assay
1 mL of bacterial suspension containing 106 CFU/mL P. aeruginosa PAO1 (prepared from fresh overnight culture) was grown in 15 mL MHB medium. After 24 h, the culture was centrifuged at 5000 rpm for 7 min, and then the bacterial pellet suspended in 5 mL fresh culture media and incubated again in the presence of ½ MIC of each compound at 37 °C for 24 h. Pyocyanin was extracted from the supernatant via adding 2 mL chloroform followed by mixing with 1 mL hydrochloric acid (0.1 N). The optical density of the resultant pink solution was measured at 388 nm (Chatterjee et al. 2017). The results were compared to the positive control (P. aeruginosa + medium).
Protease assay
Supernatants of P. aeruginosa PAO1 culture (0.5 mL), grown in the absence or presence of ½ MIC each compound was added to the tubes containing 1 mL skimmed milk (1.5%), and the tubes were incubated at 37 °C. After 2 h, proteolytic degradation of skimmed milk was quantified by measuring the turbidity at 500 nm (El-Mowafy et al. 2014; Chatterjee et al. 2017). The results were compared to the positive control (P. aeruginosa + medium + skimmed milk) and negative control (medium + skimmed milk). The resulted absorbance values were normalized to % inhibition for protease activity through the following equation:
Pyoverdine assay
For the analysis of pyoverdine development, each compound was added to the fortified MHB P. aeruginosa culture with the final concentration of 1/2 MIC. Then the tubes were incubated at 37 °C for 12 h in dark conditions. After centrifugation at 5000 rpm, 200 μL of the culture supernatants was inoculated into a black 96-well plate. The fluorescence intensity was measured with excitation at 400 ± 10 nm and emission at 460 ± 10 nm (Thomann et al. 2016). The results were compared with the positive control (P. aeruginosa + medium). % Inhibition of pyoverdine and pyocyanin were also calculated according to the following equation:
where A indicates the absorption of the tested compound in both equations.
Potentiation effect of ketoprofen and the derivatives with tobramycin against sessile bacteria
To evaluate the potentiation effect of the compounds with tobramycin, Thomann et al.’s method was employed with some modifications. Each compound (with the concentration of MIC) was added to the solution containing tobramycin (2 μg/mL) in fortified MHB. Correspondingly, the microbial culture was prepared in a bottom flat 96-well microtiter plate according to the biofilm formation assay and the medium was replaced after 24 h. Next, after 12 h more incubation, the supernatant of cultured P. aeruginosa was removed and 200 µl of the provided solution was added to the wells.
After a 12 h exposure to the compounds, the bacterial culture medium was replaced with 200 µL fresh MHB. Subsequently, 20 µL TTC solution (5 mg/mL) was added and incubated for another 4 h at 37 °C (Thomann et al. 2016). The absorbance of the formed red color was recorded at 450 nm. The results were compared to a positive control (MHB containing P. aeruginosa PAO1 + DMSO) and tobramycin control (MHB containing P. aeruginsa PAO1 + DMSO + tobramycin).
Molecular modeling
All computations were carried out through a series of software including ViewerLite 4.2, ChemOffice Professional 16 (Perkin Elmer, USA), HyperChem 7.0, and AutoDockTools (version 1.5.4).
To assess the inhibitory activity of ketoprofen and its derivatives against PqsR, compounds (including G20, G69, G70, and ketoprofen R and S isomers) were drawn by ChemOffice software, separately. The molecule energy was minimized with the HyperChem program using the AM1 semi-empirical method.
The 3D structures of PqsR were taken out from the Protein Data Bank (PDB) with the ID code of 4JVD (Ilangovan et al. 2013). The co-crystallized ligand of the protein was deleted; then, the protein molecule was modified by adding all hydrogen atoms and Kollman charges in the rigid form. The grid box was limited to the amino acids involved in the active site, and the docking-parameter files were formed using the Lamarckian genetic algorithm.
The molecules with optimized energy and flexible bonds were separately docked in the active site of PqsR. The number of runs was set to 50 replications and the other settings were set as defaults. The outcomes of the docking computations were ranked by binding energy. The conformations, interactions, and possible hydrogen binding between the protein and the molecules were evaluated by ViewerLite (Soheili et al. 2015).
Statistical analysis
The influence of ketoprofen and its derivatives on P. aeruginosa biofilm formation and virulence factors production was analyzed using SPSS software with one-way ANOVA according to Tamhane or Tukey’s Multiple Comparison Tests at P ˂ 0.05. The results were calculated as the means ± standard errors after three repetitions.
Results and discussion
Bacterial QSIs and antagonists are suitable potential therapeutic agents to manage infectious diseases. Synthetic AHL analogs, Quinolone- and quinazolinone-based derivatives, furanone derivatives, and many natural compounds, mainly of plant origin, have been described to possess QSI activity (Ding et al. 2011; Galloway et al. 2011; Miandji et al. 2012; Soheili et al. 2019). Moreover, a variety of previously discovered medicines have indicated QS modulating activity. For example, it has been established that azithromycin interferes with the QS circuit of P. aeruginosa (Tateda et al. 2001). Other antibiotics such as ceftazidime, ciprofloxacin, and tobramycin have also been described to reduce the production of an extensive range of QS-dependent virulence factors (Skindersoe et al. 2008; Galloway et al. 2011).
NSAIDs family are also among the non-antibiotic drugs which have been indicated as having antimicrobial and anti-pseudomonal effects (Bandara et al. 2004; Ulusoy and Bosgelmez-Tinaz 2013). The antibacterial activity of NSAIDs might be due to the intervention in bacterial DNA synthesis (Dastidar et al. 2000). In addition to exploring their potential for antibacterial activity, researchers have evaluated the effects of NSAIDs on biofilms formation and also other factors related to bacterial virulence. The decrease in biofilm matrix components (such as teichoic acids, extracellular polysaccharides, and proteins), modification of cell surface hydrophobicity, or the inhibitory effect on the QS circuit are the factors that must be considered (Oprea and Moga 2015). Diclofenac sodium is one of the NSAIDs that presented inhibitory activity against biofilm formation of P. aeruginosa (Umaru et al. 2009). Moreover, many studies showed that sub-MIC concentrations of diclofenac similarly decreased twitching and motility, as well as protease and hemolytic activities, and caused a significant reduction in the production of virulence factors like pyocyanin and pyoverdine (Bandara et al. 2004; Dutta et al. 2007; Abbas et al. 2012; Abbas 2015; Padma and Yalavarthy 2015; e Silva and Silva 2018). Other investigations also showed antibacterial activity of ibuprofen ranging from bacteriostatic to bactericidal as well as its synergy with other antimicrobials, and also had a significant disruptive effect on P. aeruginosa mature biofilm (Khalaf et al. 2015; Obad et al. 2015; Chan et al. 2017; Shah et al. 2018). Similarly, in another study it was revealed that meloxicam has a significant inhibitory effect on P. aeruginosa biofilm development, and also it has the ability to to considerably inhibit motilities, gene expression and QS-related virulence factors production (She et al. 2018). Moreover, salicylic acid and aspirin reduce the motility, swarming, twitching and decrease the production of several potential virulence factors of P. aeruginosa. Both of them also prevent adhesion and at therapeutic levels, decrease the biofilm formation (Kunin et al. 1995; Prithiviraj et al. 2005; Bandara et al. 2006; Chow et al. 2011; El-Mowafy et al. 2014). However, a few reports (Abbas et al. 2012; Ulusoy and Bosgelmez-Tinaz 2013; Khalaf et al. 2015) can be found in the literature about the inhibitory effects of ketoprofen on P. aeruginosa adherence, biofilm formation, biofilm destruction and swarming motility.
Minimum inhibitory concentration test
The probable MIC of each synthetic compound and ketoprofen was estimated. MIC was measured as the minimum concentration with inhibitory effects against the growth progress of P. aeruginosa (Table1). Thus, the minimum concentration of each tested compound, without any change in color to red, was selected as the MIC. The results indicated that G77 is the most potent substance. Moreover, based on the MIC results none of these compounds were effective enough to be used as a probable antibiotic; they can be utilized as a co-treatment with other potent compounds.
However, what is of importance is not the lethal effects of the compounds, but its effects on the disruption of the bacterial QS system. Therefore, the anti-biofilm and anti-virulence factors effects of the more effective compounds at sub-MIC concentrations were investigated.
Anti-biofilm effect of ketoprofen and the derivatives
The assessment of biofilm formation in the presence of sub-MIC concentration of ketoprofen, the synthetic derivatives, and tobramycin showed that ketoprofen, G19, G20, G21, G77, and G69 significantly (P < 0.05) inhibited biofilm formation (about 51% for ketoprofen, 76% for G19, 79% for G20, 73% for G21, 35% for G69 and 16% for G77) as compared to the positive control (Fig. 2). These results showed that G19, G20, G21, are potent anti-biofilm compounds compared to diclofenac at ¼ MIC (58.37% inhibition) as well as aspirin at ¼ MIC (50% inhibition) (El-Mowafy et al. 2014; Abbas 2015).
Virulence factors analysis
We next tested the effect of all the chosen compounds on the production of QS-controlled virulence factors including total protease, pyocyanin, and pyoverdine. Treating P. aeruginosa PAO1 with ½ MIC of all compounds (0.5 mg/mL except G77 which was used as 0.25 mg/mL) caused a significant decrease in the level of all virulence factors tested.
As shown in Fig. 3, the expression level of protease was significantly suppressed by 0.5 mg/mL of G19, G20, G21, G69, and 0.25 mg/mL of G77. In fact, at 0.5 mg/mL, 26% inhibition of protease activity for G19, 22% for G20, 24% for G21, 25% for G69 and at 0.25 mg/mL, 28% for G77 was observed. Ketoprofen did not significantly reduce protease activity (P > 0.05) as compared to the positive control. The previous studies indicated that diclofenac sodium is a more potent protease inhibitor (52.58% reduction with ¼ MIC) (Abbas 2015). Furthermore, aspirin is the most effective compound with 82% protease inhibitory at ¼ MIC (El-Mowafy et al. 2014).
The other virulence factor, pyocyanin is vital for biofilm development and infection in P. aeruginosa (Wu et al. 2016). Compared to the positive control, a significant decrease was observed in the production of pyocyanin in the samples treated with 0.25 mg/mL of G69 or 0.5 mg/mL of the other compounds (20% for G69, 30% for G19, G20, and G77, and 53% for ketoprofen) (Fig. 3). In another investigation, aspirin displayed stronger activity than ketoprofen and its synthetic derivative (El-Mowafy et al. 2014) and diclofenac is also more potent than synthetic derivatives (42.32% inhibition) (Abbas 2015). Meloxicam is almost as strong as synthetic derivatives with 32% inhibition (She et al. 2018).
Furthermore, pyoverdine concentration was also affected by these compounds. There was a significant reduction in pyoverdine production (16% for G20, 42% ketoprofen, 57% for G69 at 0.5 mg/mL and 55% for G77 at 0.25 mg/mL) as compared to the positive control group (P < 0.05) (Fig. 3). When we compared other NSAID inhibitory results, ketoprofen, G69, and G77 showed themselves to be more potent than diclofenac sodium with a 36.72% reduction in pyoverdine production (Abbas 2015). G19 and G21 did not significantly reduce pyoverdine concentration.
Potentiation of tobramycin activity against P. aeruginosa
Besides the direct antimicrobial property of NSAIDs, their association with antibiotics can lead to inhibitory or bactericidal synergistic activity against bacterial pathogens (e Silva and Silva 2018). Biofilm formation reduced the penetration and effectiveness of the antibiotic. Encapsulated cells in the biofilm are up to 1000 times more resistant to conventional antibiotics compared to the planktonic forms (Mah and O’Toole 2001). Therefore, to potentiate the antimicrobial effects of tobramycin, ketoprofen, or one of the derivatives was added to the treatment of biofilm. The MIC concentration of ketoprofen, G19, G20, G21, G69, G77 as well as tobramycin was mixed to P. aeruginosa culture in the last 12 h incubation period (after biofilm formation). Then the quantity of living bacteria was assessed through the TTC assay. The results indicated that G20, G21, G77, and ketoprofen significantly reduced the number of viable bacteria as compared to the positive control group (Fig. 4). There was no significant difference between the positive control and tobramycin alone, which is a confirmation of the ineffectiveness of antibiotics on cells surrounded by the biofilm matrix, even at the MIC level. However, the antibacterial effect of tobramycin potentiated to > 50% in the presence of some derivatives, such as G20. This effect is especially important because the eradication of biofilms after formation is almost impossible and this barrier protects the sessile bacteria from antibiotic penetration.
In silico study
The in silico study was performed to predict and evaluate the interaction of the best compounds applied in the in vitro study. The molecular modeling interaction of PqsR-ketoprofen and other synthetic derivatives revealed that G19, G20, G69, G77, and ketoprofen interact even more effectively than the natural ligands of PqsR (PQS and HHQ) (Table 2). Generally, most of the key interactions took place through the amino acids isoleucine 195, leucine 197, and leucine 207 (Figs. 5, 6). However, it should be considered that these results were achieved in static conditions and the protein was treated as a rigid form. Therefore, for accurate comparison of the compound’s efficacy, attention should be paid to experimental results. For instance, the compound G69, which was acquired as the least inhibition constant (Ki = 10.65 nM), did not act as the most effective substance (Table 2). Based on the structural comparison, it should be noted that compounds G19 and G20 are isomers and the presence of benzoyl group at position 6 is more preferable than position 8 due to the less steric hindrance and better placement in the lipophilic pocket of the protein. Moreover, the existence of electron-withdrawing groups with hydrogen bond-forming ability such as SO2Me and N3 groups can help the compounds better interact with the active site of PqsR and further inhibition of the protein.
Conclusion
In summary, our study provided new insight into the anti-QS activity of ketoprofen and its derivatives against P. aeruginosa. Although this study did not evaluate the changes in gene expression of various P. aeruginosa QS pathways, the biofilm assay and virulence factors production analysis alongside in silico data convinced us that these compounds probably act through PqsR inhibition. Furthermore, co-treatment of this opportunistic pathogen with tobramycin and ketoprofen/its derivatives along with other studies that show the antimicrobial role of NSAIDs create the idea that these compounds can be used as candidate molecules in nosocomial infections. In our study, this anti-virulent and anti-pathogenic effect was more appreciable for ketoprofen, G77, and G20 for the development of next-generation therapeutics.
Data availability
Data and materials are available as needed.
References
Abbas HA (2015) Inhibition of virulence factors of Pseudomonas aeruginosa by diclofenac sodium. Roum Arch Microbiol Immunol 74:79–85
Abbas HA, Serry FM, EL-Masry EM (2012) Combating Pseudomonas aeruginosa biofilms by potential biofilm inhibitors. Asian J Res Pharm Sci 2:66–72
Bahari S, Zeighami H, Mirshahabi H, Roudashti S, Haghi F (2017) Inhibition of Pseudomonas aeruginosa quorum sensing by subinhibitory concentrations of curcumin with gentamicin and azithromycin. J Glob Antimicrob Resist 10:21–28
Bandara B, Sankaridurg P, Willcox M (2004) Non-steroidal anti inflammatory agents decrease bacterial colonisation of contact lenses and prevent adhesion to human corneal epithelial cells. Curr Eye Res 29:245–251
Bandara MB, Zhu H, Sankaridurg PR, Willcox MD (2006) Salicylic acid reduces the production of several potential virulence factors of Pseudomonas aeruginosa associated with microbial keratitis. Invest Ophthalmol vis Sci 47:4453–4460
Bottomley MJ, Muraglia E, Bazzo R, Carfì A (2007) Molecular insights into quorum sensing in the human pathogen Pseudomonas aeruginosa from the structure of the virulence regulator LasR bound to its autoinducer. J Biol Chem 282:13592–13600
Chan EWL, Yee ZY, Raja I, Yap JKY (2017) Synergistic effect of non-steroidal anti-inflammatory drugs (NSAIDs) on antibacterial activity of cefuroxime and chloramphenicol against methicillin-resistant Staphylococcus aureus. J Glob Antimicrob Resist 10:70–74
Chatterjee M et al (2017) Mechanistic understanding of phenyllactic acid mediated inhibition of quorum sensing and biofilm development in Pseudomonas aeruginosa. Appl Microbiol Biotechnol 101:8223–8236
Chow S, Gu K, Jiang L, Nassour A (2011) Salicylic acid affects swimming, twitching and swarming motility in Pseudomonas aeruginosa, resulting in decreased biofilm formation. JEMI 15:22–29
Dastidar SG, Ganguly K, Chaudhuri K, Chakrabarty A (2000) The anti-bacterial action of diclofenac shown by inhibition of DNA synthesis. Int J Antimicrob 14:249–251
Dekimpe V, Deziel E (2009) Revisiting the quorum-sensing hierarchy in Pseudomonas aeruginosa: the transcriptional regulator RhlR regulates LasR-specific factors. Microbiology 155:712–723
Ding X et al (2011) Screening for novel quorum-sensing inhibitors to interfere with the formation of Pseudomonas aeruginosa biofilm. J Med Microbiol 60:1827–1834
Dutta NK et al (2007) Potential management of resistant microbial infections with a novel non-antibiotic: the anti-inflammatory drug diclofenac sodium. Int J Antimicrob 30:242–249
e Silva AAdL, Silva PM (2018) Non-antibiotic compounds: the activity of the NSAID diclofenac on bacteria—a review. Int J Curr Microbiol App Sci 7:340–351
El-Mowafy SA, El Galil KHA, El-Messery SM, Shaaban MI (2014) Aspirin is an efficient inhibitor of quorum sensing, virulence and toxins in Pseudomonas aeruginosa. Microb Pathog 74:25–32
Galloway WR, Hodgkinson JT, Bowden SD, Welch M, Spring DR (2011) Quorum sensing in gram-negative bacteria: small-molecule modulation of AHL and AI-2 quorum sensing pathways. Chem Rev 111:28–67
Geske GD, Mattmann ME, Blackwell HE (2008) Evaluation of a focused library of N-aryl l-homoserine lactones reveals a new set of potent quorum sensing modulators. Bioorg Med Chem Lett 18:5978–5981
Givskov M et al (1996) Eukaryotic interference with homoserine lactone-mediated prokaryotic signalling. J Bacteriol 178:6618–6622
Hentzer M et al (2002) Inhibition of quorum sensing in Pseudomonas aeruginosa biofilm bacteria by a halogenated furanone compound. Microbiol 148:87–102
Husain FM, Ahmad I, Al-thubiani AS, Abulreesh HH, AlHazza IM, Aqil F (2017) Leaf extracts of Mangifera indica L. inhibit quorum sensing–regulated production of virulence factors and biofilm in test bacteria. Front Microbiol 8:727
Ilangovan A et al (2013) Structural basis for native agonist and synthetic inhibitor recognition by the Pseudomonas aeruginosa quorum sensing regulator PqsR (MvfR). PLoS Pathog 9:1–17
Jakobsen TH et al (2012) Ajoene, a sulfur-rich molecule from garlic, inhibits genes controlled by quorum sensing. Antimicrob Agents Ch 56:2314–2325
Khalaf A et al (2015) Antibacterial, anti-biofilm activity of some non-steroidal anti-inflammatory drugs and N-acetyl cysteine against some biofilm producing uropathogens. Am Journal Epidemiol 3:1–9
Kim C et al (2008) Furanone derivatives as quorum-sensing antagonists of Pseudomonas aeruginosa. Appl Microbiol Biotechnol 80:37
Kunin CM, Hua TH, Bakaletz LO (1995) Effect of salicylate on expression of flagella by Escherichia coli and Proteus, Providencia, and Pseudomonas spp. Infect Immun 63:1796–1799
Mah T-FC, O’Toole GA (2001) Mechanisms of biofilm resistance to antimicrobial agents. Trends Microbiology 9:34–39
Maisuria VB, Lopez-de Los Santos Y, Tufenkji N, Déziel E (2016) Cranberry-derived proanthocyanidins impair virulence and inhibit quorum sensing of Pseudomonas aeruginosa. Sci Rep 6:30169
Miandji A et al (2012) Synthesis and biological activities of some 1, 3-benzoxazol-2 (3H)-one derivatives as anti-quorum sensing agents. Arzneimittelforschung 62:330–334
Obad J, Šušković J, Kos B (2015) Antimicrobial activity of ibuprofen: new perspectives on an “old” non-antibiotic drug. Eur J Pharm Sci 71:93–98
Oprea V, Moga D (2015) Why should be removed chronic infected abdominal synthetic meshes? A review. J Surg 2:17–23
Padma R, Yalavarthy PD (2015) Screening of diclofenac for antibacterial activity against pathogenic microorganisms. Int J Adv Pharm Bio Chem 4:554–558
Prithiviraj B et al (2005) Down regulation of virulence factors of Pseudomonas aeruginosa by salicylic acid attenuates its virulence on Arabidopsis thaliana and Caenorhabditis elegans. Infect Immun 73:5319–5328
Qais FA, Khan MS, Ahmad I (2019) Broad-spectrum quorum sensing and biofilm inhibition by green tea against gram-negative pathogenic bacteria: deciphering the role of phytocompounds through molecular modelling. Microb Pathog 126:379–392
Rasmussen TB et al (2005) Identity and effects of quorum-sensing inhibitors produced by Penicillium species. Microbiology 151:1325–1340
Reichhardt C, Parsek M (2019) Confocal laser scanning microscopy for analysis of Pseudomonas aeruginosa biofilm architecture and matrix localization. Front Microbiol 10:677
Rutherford ST, Bassler BL (2012) Bacterial quorum sensing: its role in virulence and possibilities for its control. Cold Spring Harb Perspect Med 2:a012427
Sarabhai S, Sharma P, Capalash N (2013) Ellagic acid derivatives from Terminalia chebula Retz. downregulate the expression of quorum sensing genes to attenuate Pseudomonas aeruginosa PAO1 virulence. PLoS One 8:1–11
Shah PN et al (2018) Antimicrobial activity of ibuprofen against cystic fibrosis-associated gram-negative pathogens. Antimicrob Agents Chem 62:1–22
She P et al (2018) Meloxicam inhibits biofilm formation and enhances antimicrobial agents efficacy by Pseudomonas aeruginosa. MicrobiologyOpen 7:e00545
Skindersoe ME et al (2008) Effects of antibiotics on quorum sensing in Pseudomonas aeruginosa. Antimicrob Agents Chem 52:3648–3663
Soheili V, Bazzaz BSF, Abdollahpour N, Hadizadeh F (2015) Investigation of Pseudomonas aeruginosa quorum-sensing signaling system for identifying multiple inhibitors using molecular docking and structural analysis methodology. Microb Pathog 89:73–78
Soheili V, Tajani AS, Ghodsi R, Bazzaz BSF (2019) Anti-PqsR compounds as next-generation antibacterial agents against Pseudomonas aeruginosa: a review. Eur J Med Chem 172:26–35
Tateda K, Comte R, Pechere J-C, Köhler T, Yamaguchi K, Van Delden C (2001) Azithromycin inhibits quorum sensing in Pseudomonas aeruginosa. Antimicrob Agents Chem 45:1930–1933
Thomann A, de Mello Martins AG, Brengel C, Empting M, Hartmann RW (2016) Application of dual inhibition concept within looped autoregulatory systems toward antivirulence agents against Pseudomonas aeruginosa infections. ACS Chem Biol 11:1279–1286
Ulusoy S, Bosgelmez-Tinaz G (2013) Nonsteroidal anti-inflammatory drugs reduce the production of quorum sensing regulated virulence factors and swarming motility in human pathogen Pseudomonas aeruginosa. Drug Res (stuttg) 63:409–413
Umaru T, Nwamba CO, Kolo I, Nwodo UU (2009) Antimicrobial activity of non-steroidal anti-inflammatory drugs with respect to immunological response: diclofenac sodium as a case study. Afr J Biotechnol 8:7333–7339
Van Delden C, Iglewski BH (1998) Cell-to-cell signaling and Pseudomonas aeruginosa infections. Emerg Infect Dis 4:551
Wu S, Liu G, Jin W, Xiu P, Sun C (2016) Antibiofilm and anti-infection of a marine bacterial exopolysaccharide against Pseudomonas aeruginosa. Front Microbiol 7:102
Zarghi A, Ghodsi R (2010) Design, synthesis, and biological evaluation of ketoprofen analogs as potent cyclooxygenase-2 inhibitors. Bioorg Med Chem 18:5855–5860
Acknowledgement
The results described in this paper were part of pharmacy students thesis.
Funding
No funding.
Author information
Authors and Affiliations
Contributions
VS and BSFB designed the study and revised the manuscript; EJ and MD performed the experiment and collected the data; RG coordinated the study; AST and SG analyzed the data and wrote the manuscript.
Corresponding authors
Ethics declarations
Conflict of interest
The authors declare that the research was conducted in the absence of any commercial or financial relationships that could be construed as a potential conflict of interest.
Ethical approval
Not applicable.
Consent to participate
Not applicable.
Consent for publication
Not applicable.
Additional information
Communicated by Erko Stackebrandt.
Publisher's Note
Springer Nature remains neutral with regard to jurisdictional claims in published maps and institutional affiliations.
Rights and permissions
About this article
Cite this article
Tajani, A.S., Jangi, E., Davodi, M. et al. Anti-quorum sensing potential of ketoprofen and its derivatives against Pseudomonas aeruginosa: insights to in silico and in vitro studies. Arch Microbiol 203, 5123–5132 (2021). https://doi.org/10.1007/s00203-021-02499-w
Received:
Revised:
Accepted:
Published:
Issue Date:
DOI: https://doi.org/10.1007/s00203-021-02499-w